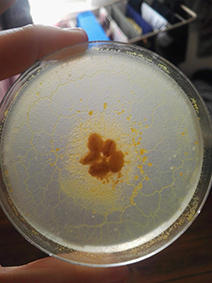

No edit summary |
No edit summary |
||
| Line 360: | Line 360: | ||
[https://youtu.be/Ur-rsnHKyc4] | [https://youtu.be/Ur-rsnHKyc4] | ||
{{#ev:youtu.be | {{#ev:youtu.be|Ur-rsnHKyc4}} | ||
Revision as of 09:56, 9 July 2018
Project Ideas
- analog animation
- jazz music
- experience dynamics of an organism
- stop motion/animation
My first Physarum polycephalum
Some thoughts and peripheral thinking about Jazz and Physarum
First thought
Jazz its difficult to define cause contains many sub-genres and improvisation its one of its key elements. / Physarum its also for me difficult to define. Its one of 700 species of slime mold, ist a procaryote organism that in order to function reunites with millions of nuclei to maximise its means.
Second thought
Jazz is essentially a improvisation musik style. It evoques the myth of resistance. Jazz focus on individual freedom and an authentic expression of oneself, as well as the concept of living in the present. / Physarum polycephalum conceive the essence of improvisation for survival. It spreads, seeks for food and in every steep recognise it self with the intention of prevail.
Third thought
Jazz interpretation involves totally recognition of the members of the band. There must be no ego. Every good played sound also depends of the effort from the other musicians. / Physarum is a millions of nuclei organism, all sharing a cell wall, all operating as a single entity. They work in group...
Fourth thought
Jazz its influenced by early forms of blues music, wich is a form of folk music wich arose in part from the work songs of the African-American slave plantations. This songs are structured around a repetitive call-response pattern. / The particularly way that Physarum grows also respond to a repetitive call-response pattern. They go two steeps forward and one backwards, then two forwards and one backwards and so on... They talk to each order und response, then grow...
SOME TEXTS, INSPIRATION AND REFERENCES...
Jazz and Existencialism By MARITHE VAN DER AA [1]
Heather Barnett TEDTalk
[2]
Jazz WIKIPEDIA
[3]
FREE PROJECT: Inflexión
Direction, design and production of a short film/music video for the Jazz band "Jazz the Roots"
JazztheRoots BandCamp Song N. 11 "Inflexión" [4]
ANIMATION_esthetic and concept:
As main concept I have chosen the myth of "the awakening" and its meanings of nature, chance, revelations, natural process, ways of existing, micro decisions and existentialism.
I collect plants and botanic stuff in order to understand and take some inspiration about micro structures and botanic growth processes so I can define aesthetics and animation lines and movements.
I am approaching to the idea of creating a king of Eden garten, some kind of reality that shows symbiotic processes and developing relations between living and non living organisms, the seekness of power and the symbols of symmetry.
I have been seeing the work of artist like:
- Remedios Varo_
Creación del mundo o microcosmos
"an avid believer in the inter-relatedness of all things and people, including the inter-weave of sound, light and image"[[5]] "video" [6]
- Hyeronimus Bosch_
"The master of the monstrous, the discoverer of the unconscious" Carl G. Jung
[7]
Video homage of the musical group Bosco to the painter in his V Centenario. Rafael Alberti's poem "El Bosco" on the details of "The Garden of Delights" that inspired the poet. [8]
- Austin Osman Spare
(30 December 1886 – 15 May 1956) was an English artist and occultist who worked as both a draughtsman and a painter. Influenced by symbolism and art nouveau his art was known for its clear use of line, and its depiction of monstrous and sexual imagery.[4] In an occult capacity, he developed idiosyncratic magical techniques including automatic writing, automatic drawing and sigilization based on his theories of the relationship between the conscious and unconscious self. [9]
EXPERIMENT
See how Physarum reacts to sound
FIRST EXPERIMENT
In order get a first approach with Physarum I read the Project "Sounds Synthesis with Slime Mould of Physarum Polycephalum" from Eduardo R. Miranda, Andrew Adamatzky and Jeff Jones [[10]]. I took the following information, quote: "voltage values were capped in a range between -40mV to 40mV, which corresponds to a normal range of plasmodium activity".
My first steep was to compare the reaction of Physarum to this amount of voltage using MaxMSP and Arduino
FIRST SETTING
Two Petri dishes with Physarum in the middle, one of them with direct voltage (0 mV to 40mV).
Results: Physarum dies :( I guess it was to hot for them.
SECOND SETTING
Two Petri dishes with Physarum in the middle, one of them with direct voltage (0 mV to 40mV). Time Lapse at home.
Time-lapse Video: [11]
THIRD SETTING
Two Petri dishes with Physarum in the middle, one of them with direct voltage (0 mV to 40mV). Time Lapse at home.
Time-lapse Video: [[12]]
SECOND APROACH
Influence Physarum with nutrients. understand his behaviour and aesthetic virtues.
Inspiration from artists known of their work with process and experimentation with nature:
ALICE DUNSEATH
ANDY GOLDSWORTHY
FOURTH EXPERIMENT
Physarum feeds on concentration of protein and carbohydrate. I peaked tree nutrients that are common on daily human nourishment and contain good levels of carbohydrates and/or proteins, also I used oat flakes because it has scientifically proven that Physarum response positively to this nutrient.
White Rice: Proteins: 6.6 gr/100 gr. Carbohydrates: 81.6 gr/100 gr.
Potatoe: Proteins: 1.7 gr/100 gr. Carbohydrates: 16 gr/100 gr.
Oat Flakes: Proteins: 14 gr/100 gr. Carbohydrates: 66.5 gr/100 gr.
The aim of this experiment is to compare the behaviour of Physarum to the food medium and measuring aspects of performance.
Agar Preparation:
In order to compare reactions prepare basic Agar 100ml distilled water 2 gr Agar
Place the Agar on a multi-well container, let dry and cut each place in half.
Agar with nutrients:
100 ml distilled water 12 gr popatoes/ rice / oat flakes Boiled 2 minutes, filter and mixt with 2 gr Agar
Place the Agar with nutrients carefully on each empty side of the multi-well container. Organice every column for one kind of nutrient Place the Physarum on the middle of both Agar.
Timelapse documentation: [[17]]
Conclutions: Physarum feels attracted mostly to potatoes
FIFTH EXPERIMENT
Mixture of potatoes and oat flakes
Agar Preparation:
In order to compare reactions prepare basic Agar
100ml distilled water 2 gr Agar
Place the Agar on a multi-well container, let dry and cut each place in half.
Agar with nutrients:
100 ml water 12 gr cooked potatoes 12 gt oat flakes (mix together, filter) 2 gr Agar Mix all together and boiled for 2 minutes
Place the Agar with nutrients carefully on each empty side of the multi-well container.
Timelapse documentation: [[18]]
I feed also Physarum with just this combination of nutrients and conclude that it is growing rapidly, strong and yellowish as normal.
SIXTH EXPERIMENT
How Physarum reacts to a super nutrient in form of a pattern.
Agar Preparation:
In order to compare reactions prepare basic Agar
100ml distilled water 2 gr Agar
Agar with super nutrient:
100 ml from liquid taken from the mixture of Oats and raw Potatoes (24 Hours rest).
Tryptone/Peptone 0,10 gr.
Glucoce 0,15 gr.
Place the basic Agar on a Petridish, let it dry and then draw a pattern on the top with the Agar that contains a super nutrient, let dry and place Physarum
Timelapse documentation: [19]
SEVENTH EXPERIMENT
Try to make Physarum feed and grow from the Super nutrient prepare on Experiment 6.
Agar with super nutrient:
100 ml from liquid taken from the mixture of Oats and raw Potatoes (24 Hours rest).
Tryptone/Peptone 0,10 gr.
Glucoce 0,15 gr.
Physarum reaction after 2 days:
In the nutrient it is also growing a bacteria, generally Physarum looks frail.
In most cases the bacteria occupied more space than Physarum
In a total of 14 cases, only 3 barely survived and 2 remained strong.
These last two were previously fed with the nutrient of experiment 5.
I took one of this, feed it with oat flakes and experiment with direct light.
TimeLapse:
[20]
Second TimeLapse using 9 LED lights located in line from below:
VideoService "youtu.be" not recognized.
EIGHTH EXPERIMENT
The purpose of this experiment is to improve the resistance of Physarum. Also to trained it to feed on a proven and previously accepted nutrient. On the FIFTH EXPERIMENT it was observed that after 5 days with potatoe and oat nutrients Physarum was growing rapidly, strong and yellowish as normal.
Agar with nutrients from the FIFTH EXPERIMENT:
100 ml water 12 gr cooked potatoes 12 gt oat flakes (mix together, filter) 2 gr Agar Mix all together and boiled for 2 minutes
I place the survivors of the last experiment on this new nutrient and observe that 9 of 12 cases are responding positiv to this environment.